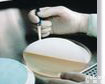
<em>碘盐</em>含碘量<em>速测</em>盒

BV2-ZYD-DYH碘盐含碘量速测盒,碘量速测盒
- 产地:中国大陆
- 供应商:承德正强仪表销售有限公司
- 供应商报价:电议
- 标签:BV2-ZYD-DYH碘盐含碘量速测盒,碘量速测盒,农业食品,食品检测仪器,供应BV2-ZYD-DYH碘盐含碘量速测盒,碘量速测盒,承德正强仪表销售有限公司
BV2-ZYD-DYH碘盐含碘量速测盒
【检 测 原 理】
碘与碘盐试剂反应产生颜色,颜色深浅与碘含量成正比,与标准比色卡对比可确定碘含量。
【检 测 步 骤】
取盐样少许于白纸上,在 0.5cm 高度处,慢慢滴上试剂 1 滴,试剂立即与食盐中的碘剂发生化学反应而显色(蓝紫色),待颜色稳定后与标准比色板对照,找到与色阶相同或相近的色点,色点下标示的含量即为食盐中碘的含量。国家标准要求 20-30mg/kg。
【注 意 事 项】
本方法只适用于检测添加碘酸钾的食盐中的碘,不适用海藻碘盐和四川井盐。
【储藏条件与有效期】
试剂避光常温保存,有效期为 1 年。